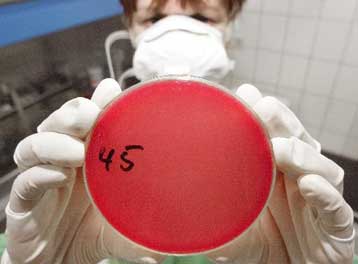
Ίχνη άνθρακα σε προξενείο των ΗΠΑ στο Πακιστάν δείχνουν οι πρώτες εξετάσεις

Για τον διάδοχο του Τζουλιάνι ψηφίζουν οι πολίτες της Νέας Υόρκης
Στις κάλπες προσέρχονται από τις πρώτες πρωινές ώρες της Τρίτης οι κάτοικοι της Νέας Υόρκης προκειμένου να αναδείξουν τον επόμενο δήμαρχο της πόλης τους. Οι τελευταίες δημοσκοπήσεις έδειξαν ότι η μάχη μεταξύ των δύο υποψηφίων θα είναι σκληρή.

Αριθμός Πιστοποίησης Μ.Η.Τ.232442
Αριθμός Πιστοποίησης Μ.Η.Τ.232442